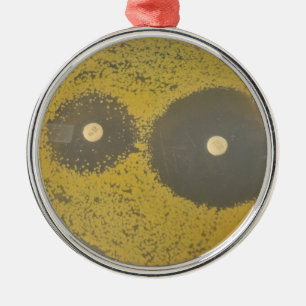
Ornement Métallique Susceptibilité antibiotique bactérienne

Microbiologie Ornements & Décorations de Noël
42 résultats
Ornement de microbiologie d'amour de paix
Prix24,95 €
Décoration En Céramique Microbiologie
Prix22,00 €
Ornement Flocon De Neige Virus magnifié
Prix28,20 €
Décoration En Céramique Virus
Prix20,80 €
Ornement cryptococcal
Prix26,25 €
Vous ne trouvez pas ce que vous recherchez ?
La Promesse Zazzle
Garantie Coup de Coeur
Vous ne l'aimez pas ? Nous le reprenons ! 30 jours pour choisir, notre "Garantie 100% coup de cœur".
Livraison Internationale Simplifiée
Expédition sans soucis, sans frais cachés. Nous couvrons les frais de douane.
Achats Sécurisés Garantis
Paiement 100% sécurisé grâce au cryptage SSL.
Avis sur la recherche
Si vous avez besoin d'assistance ou si vous avez une question, consultez notre Aide
Articles vus récemment